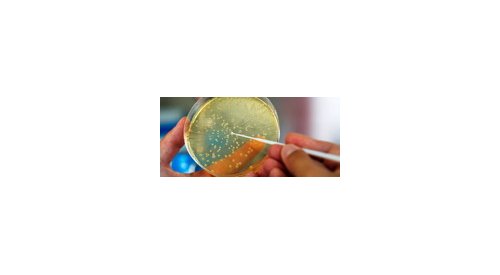

Science, R&D
Japanese-French seminar highlights predictability of anti-oxidative properties
The 2013 edition of the Japanese-French seminar organized by the Scientific department of the Embassy of France in Japan and LVMH...
“Tomorrow’s skin care will be based on a holistic approach,” Dominique Sigaudo-Roussel, Institute of Biology...
Mrs Dominique Sigaudo-Roussel, a researcher at the Institute of Biology and Chemistry of Proteins of Lyon, has been studying for...
"Our water treatment process increases the performance of formulated products," Dr. Philippe...
While the use of water in the cosmetics industry emerges as both a technical and environmental issue, Premium Beauty News has asked Dr....
New alternative method to identify allergenic substances
Promega and BASF have jointly developed a new method on detecting the allergenic potential of substances. Using a newly developed cell...
Nanomaterials, where do we stand?
At the last session of “Les Matinales de la cosmétique”, the monthly event organized in Paris by SRC Consulting, Professor Philippe...
Healing and dermocosmetology
The 26th European Dermocosmetology Days organized this year on the theme of healing, gathered more than 200 people, on 7 and 8 February...
"Ultra customization of products is the emerging trend," Jérôme Lamartine, Université Claude Bernard Lyon...
Premium Beauty News met Jérôme Lamartine, Professor and Researcher in the Department of Biology at the University Claude Bernard Lyon 1,...
"The theme of healing is the link between clinical dermatology and cosmetology," Dominique Bouvier,...
On 7 and 8 February next will take place in Lyon the 26th European Dermocosmetology Days organized by the European Centre of...
Senescence and skin: what progress?
The Jean-Paul Marty Days, the annual scientific meeting organized by the French Society of Cosmetology (Société Française de Cosmétologie,...
Study highlights experience-related changes in the brain of perfume creators
According to a study published in the issue dated 12 December 2012 of the NeuroImage journal, areas of the brain that are associated...